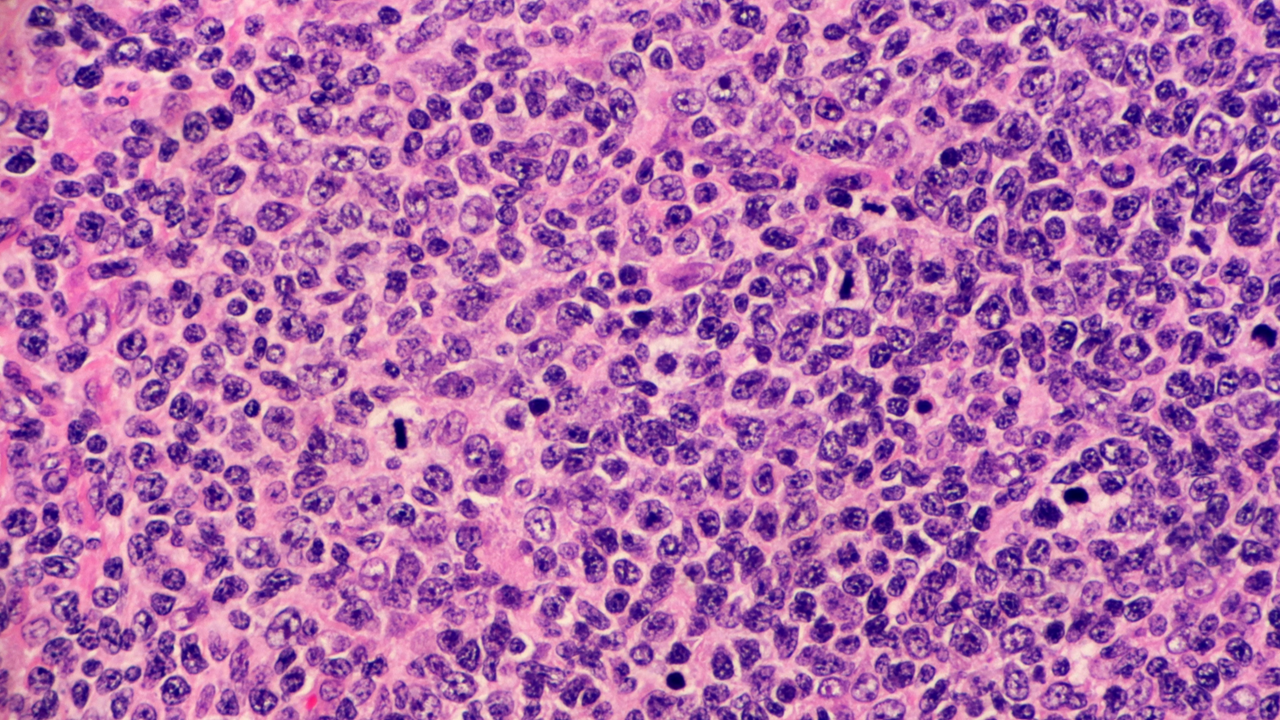
LF R/R: tafasitamab cumplió con su objetivo primario de SLP, estudio inMIND

Tafasitamab mostró resultados prometedores para el tratamiento del linfoma folicular en recaída o refractario (LF R/R), mejorando la supervivencia libre de progresión (SLP) y sin presentar nuevas señales de seguridad
Incyte anunció los resultados positivos del estudio pivotal inMIND, un fase III, global, doble ciego, aleatorizado y controlado. El estudio evaluó la eficacia y seguridad de tafasitamab, un anticuerpo monoclonal humanizado modificado que va dirigido a CD19, en combinación con lenalidomida y rituximab, en pacientes con LF R/R de grado 1 a 3a o linfoma de la zona marginal nodal, esplénico o extranodal R/R. En el estudio participaron un total de 654 adultos (edad ≥18 años). Los hallazgos sugieren que esta combinación podría representar un nuevo enfoque en el tratamiento de esta forma común de linfoma no Hodgkin de crecimiento lento.
Según la evaluación del investigador, el estudio cumplió su objetivo primario de SLP en pacientes con LF R/R, demostrando que la adición de tafasitamab a la terapia estándar podría ofrecer una mejora significativa en el control de la enfermedad; mientras que los objetivos secundarios fueron la SLP en población general, así como la respuesta completa a la tomografía por emisión de positrones (PET-CR) y la supervivencia global (SG) en la población con LF R/R. Crucialmente, no se observaron nuevas señales de seguridad con tafasitamab.
Ante estos resultados positivos, Incyte planea presentar una solicitud suplementaria de licencia de productos biológicos antes de fin de año.
Tafasitamab fue aprobado en combinación con lenalidomida por la FDA y la EMA en 2020 y 2021 respectivamente, para pacientes adultos con linfoma difuso de células B grandes (LDCBG) recidivante o refractario no especificado de otra manera, incluido el LDCBG que surge de un linfoma de bajo grado, y que no son elegibles para un trasplante autólogo de células madre.
Fuente consultada:
Incyte Announces Positive Topline Results from Pivotal Study of Tafasitamab (Monjuvi®) in Relapsed or Refractory Follicular Lymphoma. https://investor.incyte.com/news-releases/news-release-details/incyte-announces-positive-topline-results-pivotal-study. Comunicado de prensa. Acceso el 19 de agosto de 2024.
Noticia redactada por Karem Vázquez
Para aclaraciones y comentarios contactar al correo [email protected]
¿No tienes una cuenta? Regístrate